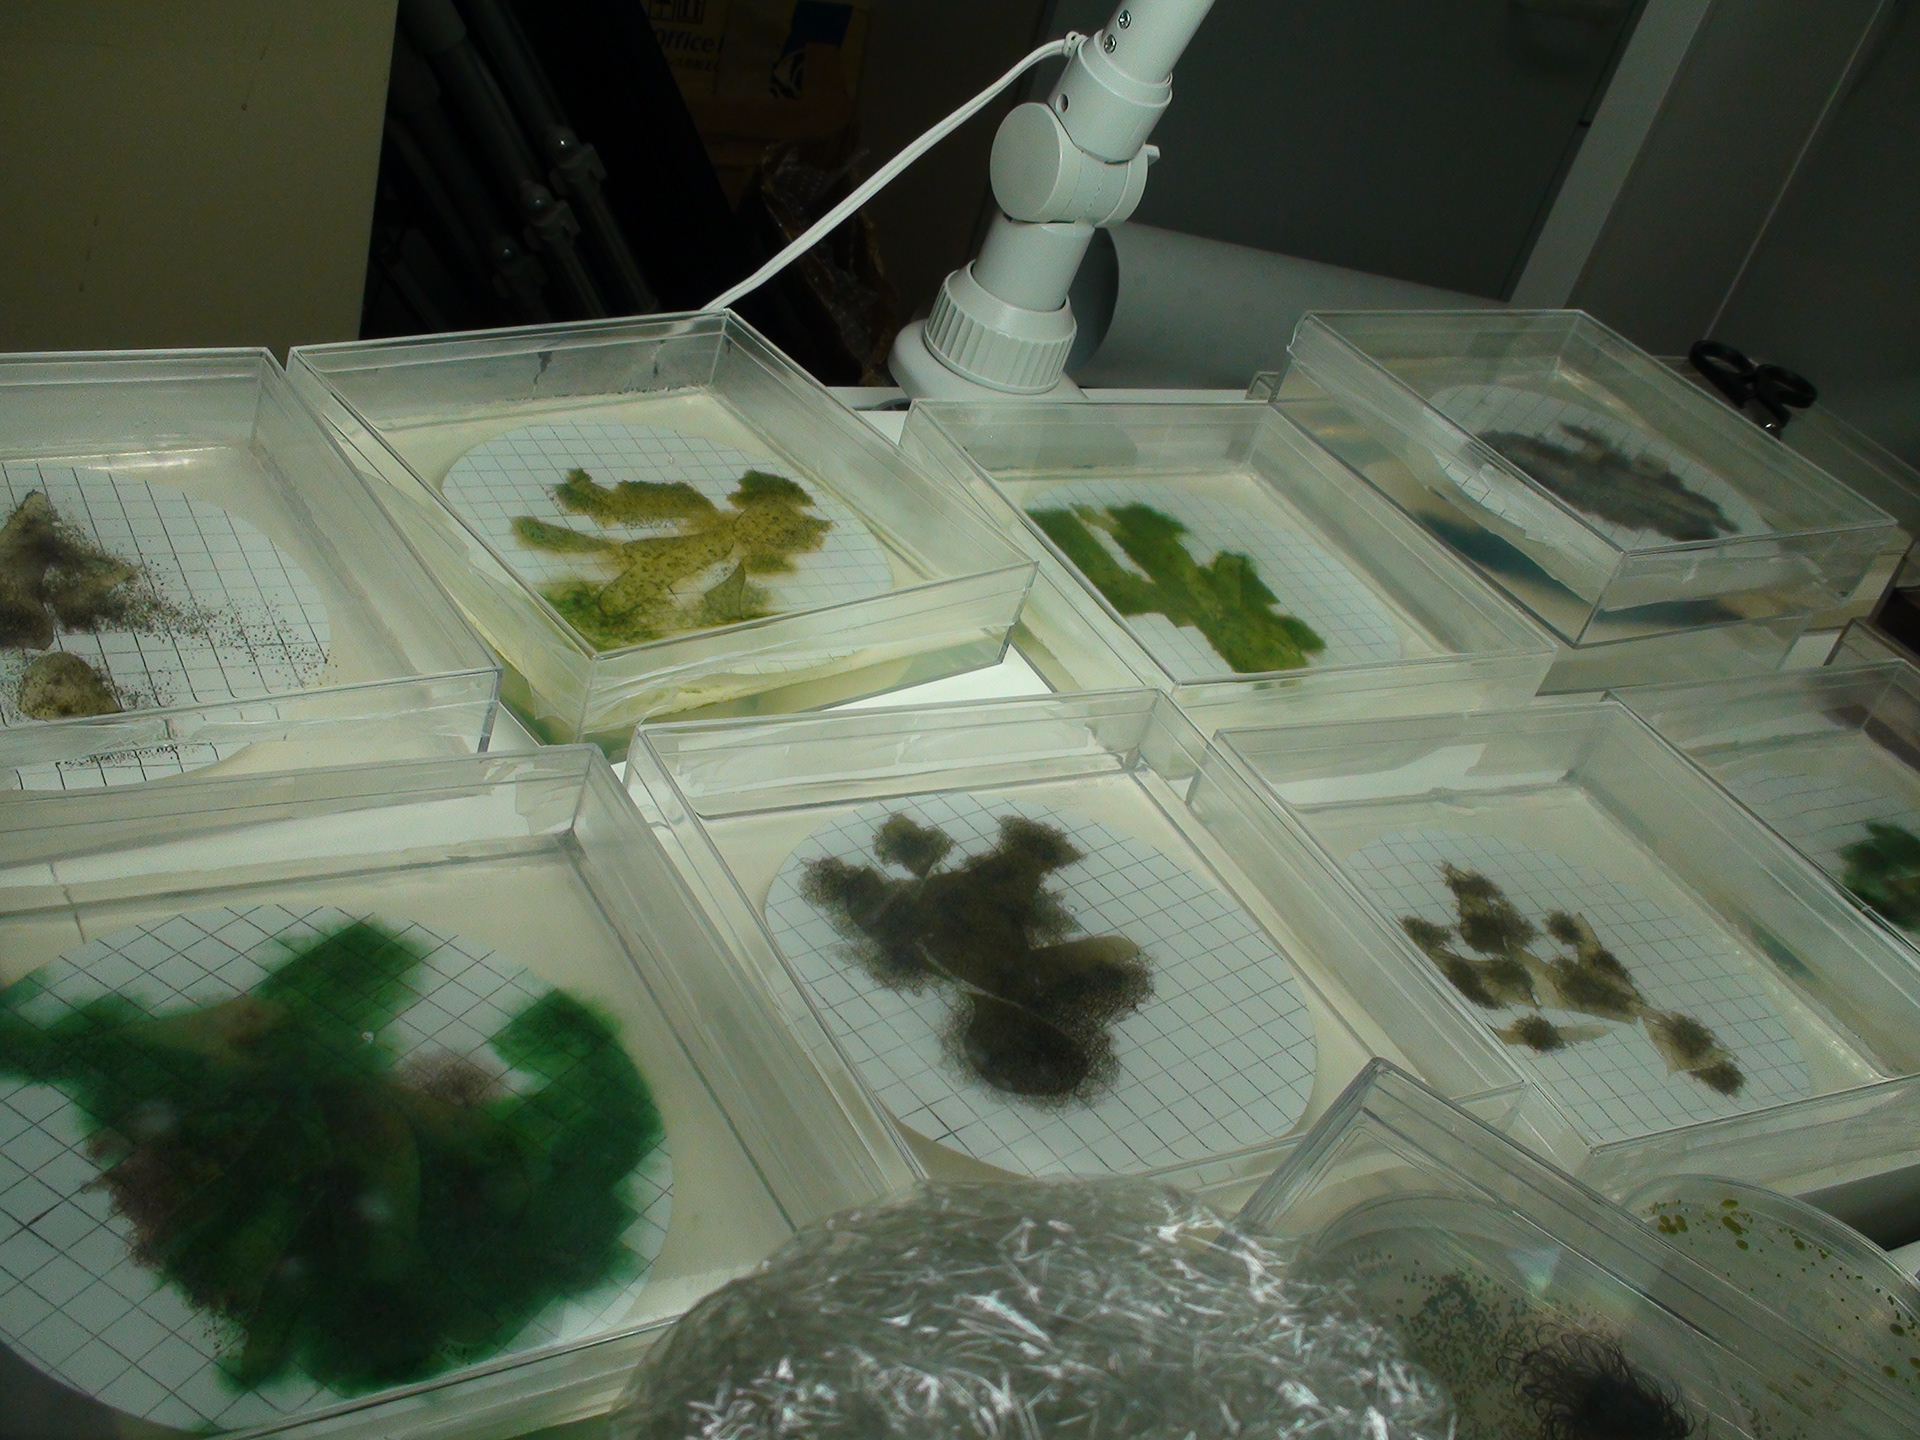

CyanoScreen
2009, 2013

















2009 In 'Boundary Garden' at a group exhibition, "Utsurobune", The Okamoto Taro Museum, Kawasaki


Making process